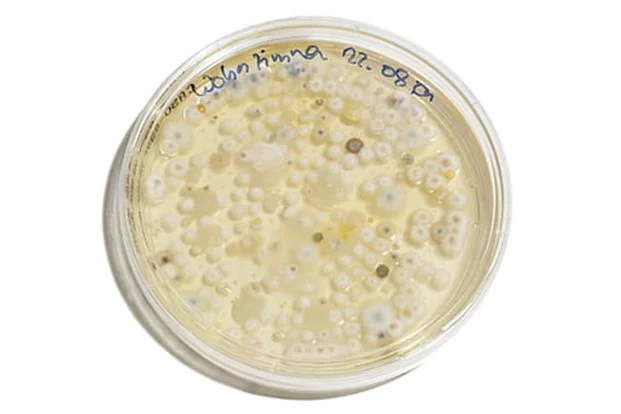
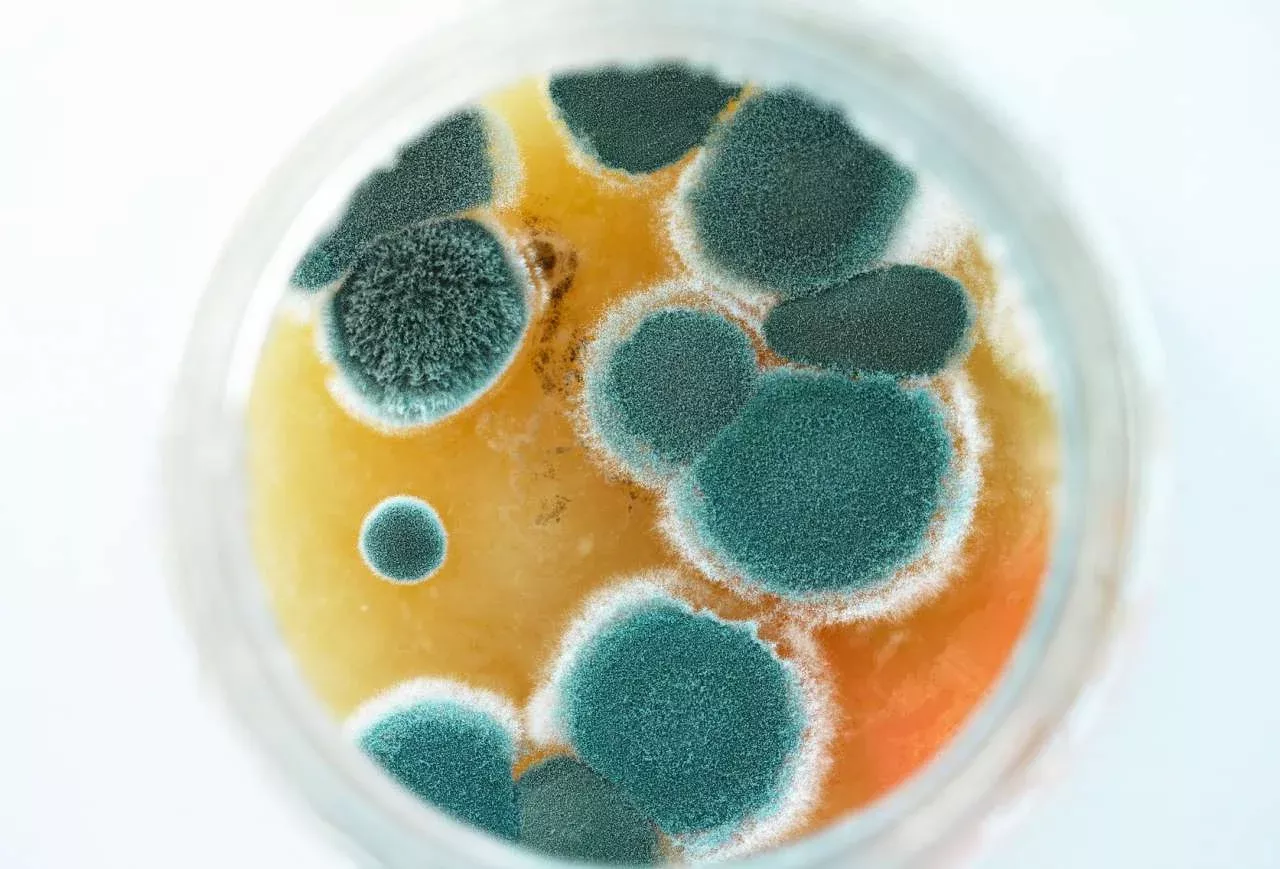

Themenüberblick
Schimmelarten in Innenräumen – Bestimmung, Gefährdung und Entfernung
Schimmelarten im Haus – wie man sie erkennt und entfernt
Was sind Schimmelpilze?

→ Allergene Wirkung, wenn Schimmelpilze über Augen oder Atemwege aufgenommen werden
Wie sehen Schimmelpilze im Allgemeinen aus und wie verbreiten sie sich?
Welche Schimmelpilzarten gibt es?
Welche Schimmelpilzarten existieren in Wohnräumen?
Um Schimmel nachhaltig und korrekt aus den vier Wänden zu entfernen, ist es wichtig die verschiedenen Schimmelarten zu kennen. Denn diese unterscheiden sich erheblich in ihrem Aussehen, ihrer Ausbreitung und den gesundheitlichen Risiken.
Im Folgenden wollen wir Sie über das Aussehen, die Verbreitung und die gesundheitlichen Risiken der jeweiligen Schimmelpilzart aufklären.
Schwarzer Schimmel

Gelber Schimmel

Roter Schimmel
Weißer Schimmel
Grüner Schimmel

Wie entfernt man die verschiedenen Schimmelpilzarten richtig?

Was sind Symptome für Schimmelpilze im Innenraum?

→ Kopfschmerzen
Kurzübersicht über die verschiedenen Schimmelpilzarten in Innenräumen
Jetzt Lüftungslösung anfragen


Ich bin Katja und als Gesundheitsexpertin beschäftige ich mich mit der Wirkung der Luftqualität auf unsere Gesundheit. Das richtige Lüften ist ein entscheidender Faktor für ein gesundes Raumklima. Durch die Zusammenarbeit mit Luftbude möchte ich mit meiner Expertise dazu beitragen, dass Sie und Ihre Familie sich in Ihrem Zuhause rundum wohlfühlen und gesund bleiben.
Quellennachweis
Für diesen Artikel wurden Erfahrungswerte mehrerer Lüftungsexperten, Bausachverständiger, Handwerker sowie Hersteller aufgearbeitet und zusammengefasst. Als Grundlage dienen hierfür aktuelle Normen, Gutachten sowie neutrale Prüfprotokolle unabhängiger Messdienstleister.









Google
5 von 5Trusted Shops
4.2 von 5Idealo
5 von 5Kununu
4.9 von 5Proven Expert
4.73 von 5